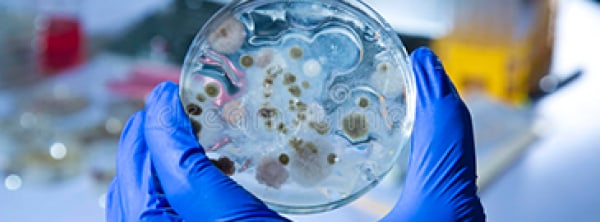

Melford
Melford Laboratories is a trusted supplier of high-quality biochemical reagents and specialty chemicals for research and industrial applications. With a commitment to excellence, we provide scientists and businesses with reliable, high-purity products that support advancements in life sciences, pharmaceuticals, and biotechnology.
Founded on principles of quality, innovation, and customer satisfaction, Melford Laboratories has built a reputation for delivering products that meet stringent industry standards. Our extensive catalog includes biochemical reagents, fine chemicals, and custom solutions tailored to the specific needs of researchers and manufacturers worldwide.
We take pride in our rigorous quality control processes, ensuring that every product undergoes thorough testing and verification. Our team of experts works closely with customers to provide technical support, guidance, and customized formulations, fostering long-term partnerships built on trust and performance.
At Melford Laboratories, we are dedicated to driving scientific progress by supplying the essential materials that empower innovation. Whether you require standard biochemical reagents or specialized compounds, we are committed to delivering excellence with every order.
- About
- Products
- Promotions
Top Categories
Featured Products
Catalog Number 30017923
Catalog Number 30018662
Catalog Number 30018358
Catalog Number 30018702
Catalog Number 30018429
Catalog Number 30018039
Catalog Number 30017984
Catalog Number 30018687